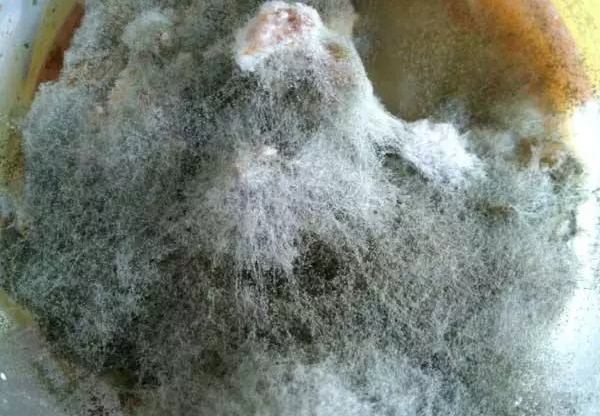
植物霉菌處理

快速导览
記得我第一次發現陽台上的盆栽長出白色絨毛時,還以為是什麼新品種的裝飾。直到葉片開始發黃枯萎,我才驚覺這可不是什麼好東西。植物霉菌就像是不請自來的麻煩客人,一旦住下就很難請走。
什麼是植物霉菌?為什麼它偏愛你的綠色夥伴
植物霉菌其實是真菌的一種,它們透過微小的孢子飄散在空氣中,尋找適合的生長環境。潮濕、通風不良的環境簡直就是它們的天堂。我曾經有一盆心愛的非洲堇,就是因為放在浴室時間太長,結果整個根部都發霉了。
這些霉菌不只影響美觀,更會搶走植物的養分,甚至釋放有害物質。最麻煩的是,它們的繁殖速度快得驚人,一個不小心就會蔓延到其他植物。
常見植物霉菌類型與識別技巧

根據我的經驗,居家植物最常遇到的霉菌有以下幾種:
| 霉菌類型 | 外觀特徵 | 好發植物 | 危險程度 |
|---|---|---|---|
| 白粉病 | 葉面白色粉末狀 | 玫瑰、黃瓜、南瓜 | ★★★☆☆ |
| 灰霉病 | 灰色絨毛狀霉層 | 草莓、番茄、觀葉植物 | ★★★★☆ |
| 黑霉病 | 黑色煤煙狀斑點 | 柑橘類、室內觀葉植物 | ★★☆☆☆ |
| 根腐病 | 根部變黑腐爛 | 多肉植物、蘭花 | ★★★★★ |
說實在的,我第一次看到白粉病時,還以為是誰在葉子上撒了麵粉。直到發現葉片開始捲曲,才意識到問題的嚴重性。這種植物霉菌特別喜歡在晝夜溫差大的季節出現,我的玫瑰就曾經中招過。
緊急處理:發現霉菌的第一時間該做什麼
當你發現植物感染霉菌時,最重要的是保持冷靜。我記得第一次看到整個盆栽都被霉菌覆蓋時,差點想把整盆植物都扔掉。但其實只要處理得當,很多植物都是可以救回來的。
立即將患病植物隔離是最關鍵的一步。我曾經犯過一個錯誤,就是把感染的植物和其他健康植物放在一起處理,結果導致更多植物遭殃。現在我都會準備一個專門的「隔離區」,用來處理生病的植物。
DIY天然防治法:廚房裡就找得到的解決方案
與其馬上使用化學藥劑,我通常會先嘗試一些天然的方法。這些方法雖然見效較慢,但對植物和環境都比較友善。
小蘇打水是我最常用的配方:一茶匙小蘇打加上幾滴植物油和少量肥皂水,混合在1公升的水中。每週噴灑一次,對防治白粉病特別有效。不過要注意濃度,太濃可能會傷到葉片。
醋水溶液也是不錯的選擇,但酸性較強,需要更謹慎使用。我通常只用於抵抗力較強的植物,而且會先在小範圍測試。
大蒜和辣椒水聽起來像是做菜,但其實對某些霉菌有抑制作用。只是氣味比較重,不適合在室內使用。
專業藥劑使用時機與選擇
當天然方法無效時,就需要考慮使用專業的殺菌劑。但說真的,我對化學藥劑一直有些抗拒,總覺得對環境不好。直到有一次我的蘭花感染嚴重的根腐病,才不得不使用專業藥劑。
選擇藥劑時要特別注意適用範圍和使用方法。我習慣先閱讀農業藥物毒物試驗所的資料,確保選擇的產品是安全有效的。
預防勝於治療:打造霉菌不喜歡的環境
經過多次與植物霉菌戰鬥的經驗,我發現預防才是最好的策略。以下是我總結的幾個重要預防措施:
通風是最重要的因素。我現在都會確保植物之間有足夠的空間,並定期開窗保持空氣流通。特別是雨季的時候,更需要加強通風。
澆水習慣也需要調整。我學會了在早晨澆水,這樣葉片有足夠時間乾燥。晚上澆水容易讓水分滯留,成為霉菌的溫床。
定期檢查植物是很重要的習慣。我每週都會花時間仔細檢查每盆植物的葉片背面和土壤表面,早期發現問題就能輕鬆解決。
特殊植物的霉菌防治要點
不同植物對霉菌的抵抗力和治療方法都不同。我的多肉植物曾經因為過度澆水而感染根腐病,而蘭花則容易因為濕度過高出現各種霉菌問題。
多肉植物最怕根部積水,所以我現在都會選擇排水性特別好的土壤,並在盆底鋪一層碎石。澆水時也會特別注意,寧可乾一點也不要過濕。
觀葉植物則需要注意葉面清潔。我定期用濕布擦拭葉片,不僅能保持美觀,也能預防霉菌滋生。特別是像琴葉榕這種大葉植物,葉面容易積灰,更需要定期清潔。
常見問答:關於植物霉菌的疑難雜症

大多數植物霉菌對健康成人影響不大,但對呼吸道敏感的人或寵物可能造成不適。我建議還是要謹慎處理。
進階技巧:資深園藝愛好者的經驗談
經過多年的摸索,我發現有些小技巧特別有用。比如在土壤表面鋪一層細砂或珍珠石,可以有效地防止土壤表面的霉菌生長。
選擇抗病性強的品種也是個好方法。我現在購買新植物時,都會優先考慮當地適應性強的病種。根據台灣種苗改進協會的資料,有些品種確實天生就比較耐病。
定期修剪過密的枝葉不僅能改善通風,也能讓植物長得更好。我每個月都會花時間整理植物的形態,這已經成為一種享受。
說到底,對付植物霉菌就像是在打一場持久戰。需要耐心觀察、及時處理,最重要的是要保持預防的意識。我現在反而感謝這些經驗,讓我成為更細心的園藝愛好者。
記得,每株植物都是獨特的個體,需要不同的照顧方式。透過持續學習和實踐,你一定能夠找到最適合自己的植物養護方法。畢竟,園藝的樂趣就在於這個不斷探索的過程。